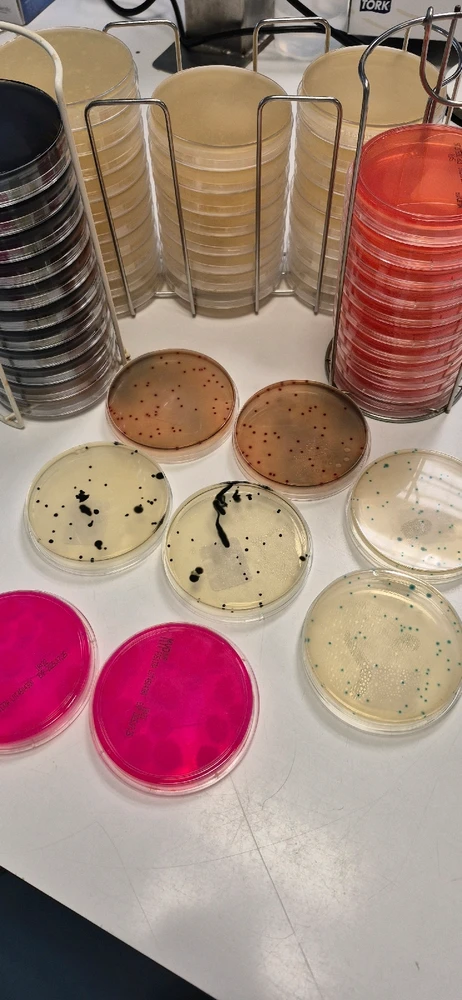
GIF geüpload door Shirley

Diverse Community
De diverse-gemeenschap, chats en discussies.
10 zielen
10 zielen
Nog geen berichten!
Ontmoet nieuwe mensen
50.000.000+ DOWNLOADS
De diverse-gemeenschap, chats en discussies.
10 zielen
10 zielen
Nog geen berichten!
Ontmoet nieuwe mensen
50.000.000+ DOWNLOADS
Gerelateerde Berichten
6ma
ISTP
Maagd
Inspire me: Wat voor draak willen jullie zien? En nu ben ik echt zo'n nerd dat "type" draken tekent. Want af en toe ben ik het "standaard" zat. (Teken maar eens meer dan 200+ draken in je leven) Ik ben gek op draken, maar wil even afwisseling in hoe ik ze teken. Even als voorbeeld ik heb al een... meer lezen
4
23
7ma
ISTP
Maagd
Oke misschien totaal uit of the box, maar wie is benieuwd wat een laboratorium medewerker ziet? Dit zijn petrischalen met diverse bacterie groei. En geen paniek! Dit zijn controles om te checken of ons proces werkt, dus groei = goed
9
10
3ma
ISTP
Maagd
Er worden diverse optredens gehouden in Rockcafé Lazaru's. Als je in de buurt woont een leuke weekend activiteit? (bewerkt)
2
7
7ma
ISTP
Maagd
Ik kreeg ooit de vraag van een match en die vroeg wat maakt jou een nerd. En ik had echt geen idee wat ik moest antwoorden dus zij ik: ik heb een verzameling van spulletjes van diverse games. Tja hoe definiëer je een "nerd" eigenlijk dan? Is dit "nerdy" genoeg?

39
19
1j
ENTJ
Schorpioen
In een andere datingapp heb ik eens voorgesteld om een eerste kennismaking te doen in de sauna. Idee was niet alleen om die vrouw te leren kennen, maar ook de diverse sauna's in het noorden van Nederland. Uiteindelijk is dat met één vrouw gelukt en heb ik een leuke dame én nieuwe sauna mogen... meer lezen
1
16